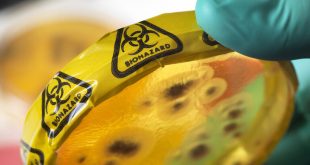

وفاة مراهق منغولي شُخّصت إصابته بالطاعون الدبلي، توفي يوم الاثنين 13 يوليو. وبحسب ما ورد، أصيب الشاب البالغ من العمر 15 عاما بالمرض المميت، بعد تناوله لحم المرموط أو “الطربغان”. وتناول الشاب اللحم المصاب بالمرض، مع اثنين من أصدقائه، ولا تزال حالتهما غير معروفة، بينما عُزل الأشخاص الذين كانوا على …
أكمل القراءة » أخبار عاجلة
- بالصور : قيادات دينية وسياسية بقداس عيد القيامة في كاتدرائية القديسة العذراء والقديس مار مينا بأستراليا
- قداسة البابا تواضروس الثاني : والرسالة البابوية لعيد القيامة المجيد 2024م!
- مزاد النور المقدس
- بنك الاستثمار الأمريكي : توقعات بزيادة احتياطي النقد الأجنبي لمصر إلى 16.2 مليار دولار في 2024
- التفاصيل الكاملة لعودة انقطاع الكهرباء وتخفيف الأحمال بمصر
- كندا تعلن عن شراكة متبادلة شاملة مع السعودية
- أونتاريو تعلن عن قرارات حاسمة لحماية حقوق الموظفين من أصحاب الأعمال
- شرطة بيل تعلن ضبط ورشة لتفكيك سيارات فخمة مسروقة في ميسيساجا
- الحكومة الكندية تقرر عودة الموظفين الحكوميين إلى العمل 3 أيام في المكتب
- إعترافات تثير الجدل لمضيفة الطيران التي قتلت ابنتها و حاولت الانتحار “بسبب هاتف في المنام لتصعد إلى السماء”
 جريدة الأهرام الجديد الكندية
جريدة الأهرام الجديد الكندية